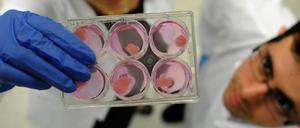
Fleisch in der Petrischale wird im Labor des israelischen Unternehmens „Aleph Farms“ entwickelt.

Die Songs von Nissim Black waren hart und schmutzig. Dann fand er zum orthodoxen Judentum.

Die Songs von Nissim Black waren hart und schmutzig. Dann fand er zum orthodoxen Judentum.

Saudi-Arabiens Kronprinz wirbt in der Region für den US-Nahost-Friedensplan. Die Interessen der Palästinenser spielen dabei kaum noch eine Rolle.

Israel und die Hamas wollen einen Krieg vermeiden. Mit jedem Angriff aus Gaza wächst jedoch die Gefahr einer großen Auseinandersetzung.

Eine 22-jährige Amerikanerin sitzt am Airport in Tel Aviv fest. Ihr werden „Boykott-Aktivitäten“ vorgeworfen

Das Industriegebiet Barkan galt als Vorzeigeprojekt. Jetzt hat vermutlich ein palästinensischer Angestellter dort zwei Israelis getötet.

Die Kanzlerin betont die Verantwortung Deutschlands im Kampf gegen den Antisemitismus, spricht aber auch Streitpunkte zwischen den Ländern an.

Das deutsch-israelische Verhältnis gilt als gut. Doch das Regierungstreffen in Jerusalem wird nicht konfliktfrei bleiben - das liegt auch am Iran. Eine Analyse.

Am 13. September 1993 schlossen Israel und die Palästinenser die Oslo-Vereinbarung. Frieden scheint heute weiter entfernt denn je.

Trump stoppt die Zahlungen für das UN-Flüchtlingshilfswerk. So will er die Autonomiebehörde zu Verhandlungen zwingen.

Bis zuletzt kämpfte Uri Avnery für eine Zweistaatenlösung im Nahostkonflikt. Nun ist der israelische Friedensaktivist im Alter von 94 Jahren gestorben.

Für Israel wird die Lage an der Grenze zu Syrien immer heikler – dort bringt sich der Iran mithilfe Assads in Stellung. Jerusalem wertet das als Bedrohung.

In Israel ist der Widerstand gegen das neue Nationalstaatsgesetz groß. Vor allem Minderheiten wie die Drusen fühlen sich nun als Bürger zweiter Klasse.

Ein Schlag ins Gesicht eines Soldaten brachten einer jungen Palästinenserin fast acht Monate Gefängnis ein. Jetzt wird sie als Symbol des Widerstands gefeiert.

Ein neues Gesetz erlaubt Israels Bildungsminister, missliebigen Gruppen Auftritte in Schulen zu untersagen. Das richtet sich vor allem gegen eine Veteranen-Organisation, die Erfahrungsberichte ehemaliger Soldaten sammelt.

Warum der jüdische Staat als erste Nation mit dem Tarnkappenbomber F-35 Einsätze fliegt und womöglich über dem Iran schon zum Einsatz kam.

Auf den Tod eines ihrer Soldaten hat die israelische Armee mit Angriffen auf militärische Ziele im Gazastreifen reagiert. Die Hamas verkündete in der Nacht zum Samstag eine Waffenruhe – doch die Lage bleibt angespannt.

Israels Parlament verabschiedet nach hitziger Debatte ein umstrittenes Gesetz. Kritiker warnen, die Araber könnten diskriminiert werden – und sehen die Demokratie in Gefahr.

Warum weder Israel noch die Hamas Interesse an einem neuen Gazakrieg haben – aber eine Eskalation nicht ausgeschlossen ist. Eine Analyse.

Von den Golanhöhen ist es nur ein Kilometer zu den Flüchlingslagern in Syrien. Verwundete lässt Israel ins Land. Alle anderen müssen draußen bleiben.

Schrei-Anfälle, schlecht behandelte Angestellte, Luxus auf Staatskosten: Seit Jahren gibt es Vorwürfe gegen die Frau des israelischen Premiers – nun wird sie angeklagt.
Israelische Forscher arbeiten daran, Fleisch zu züchten. Es soll umwelt- und tierfreundlich sein – und täuschend echt wirken und schmecken.

Für Freitag ruft die Hamas am Gazastreifen zum „Marsch der Millionen“ auf. Der Protest richtet sich gegen Israel. Wer die Hamas ist und – was die Terrorgruppe vorhat.

Extremisten feuern mehr als 150 Raketen auf Israel ab, dessen Luftwaffe schlägt zurück. Jetzt gilt offenbar eine Waffenruhe. Kann das funktionieren?

Der Gazastreifen wird mit großem Aufwand weiter abgeriegelt. Die neue Seebarriere ergänzt die Mauer und die Luftabwehr gegen Hamas-Attacken.
öffnet in neuem Tab oder Fenster